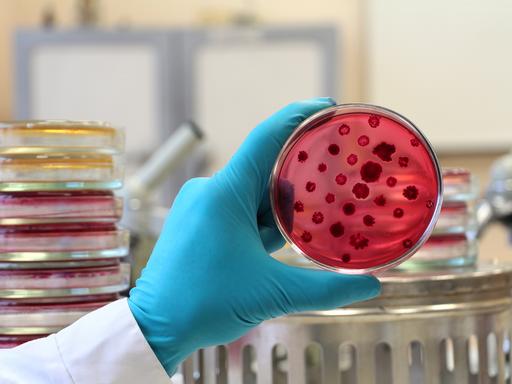
Die Hand eines Wissenschaftlers in einem weißen Laborkittel und einem blauen Handschuh hält eine geöffnete rote Petrischale die mit Bakterienkolonien bedeckt ist.
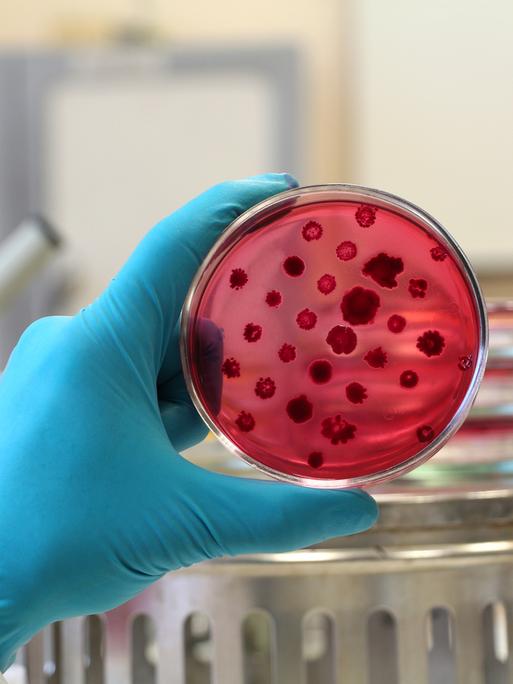
Die Hand eines Wissenschaftlers in einem weißen Laborkittel und einem blauen Handschuh hält eine geöffnete rote Petrischale die mit Bakterienkolonien bedeckt ist.

Antibiotika sind die wichtigste Waffe im Kampf gegen bakterielle Infektionen. Jeden Tag retten sie Leben. Allerdings werden sie noch immer zu häufig oder falsch eingesetzt, beispielsweise bei Virusinfektionen, gegen die sie gar nicht wirken. Auch in der Tiermast kommen viele Antibiotika zum Einsatz, die letztlich über Lebensmittel beim Menschen landen können. Durch diesen häufigen Kontakt lernen Bakterien, sich zu schützen. Sie entwickeln Resistenzen und werden zunehmend unempfindlich gegenüber gängigen Medikamenten.
Antibiotikaresistenzen könnten in Zukunft zu einer der häufigsten Todesursachen weltweit werden – noch vor Krebs. Deshalb suchen Forschende nach neuen Ansätzen gegen Antibiotikaresistenzen – unter anderem mithilfe von künstlicher Intelligenz.
Inhalt
- Antibiotikaresistenzen: Wie groß ist die Gefahr weltweit?
- Wie werden neue Antibiotika klassisch entwickelt und warum reicht das oft nicht mehr aus?
- Wie kann KI helfen, neue antibiotische Wirkstoffe zu entdecken?
- Was sind die Grenzen von KI in der Antibiotika-Forschung?
- Was lässt sich gegen Antibiotikaresistenzen sonst noch tun?
Antibiotikaresistenzen: Wie groß ist die Gefahr weltweit?
Nach Einschätzung des Robert Koch-Instituts könnten bis 2050 jährlich fast zehn Millionen Menschen weltweit an Infektionen mit antibiotikaresistenten Erregern sterben. Derzeit sind es laut Weltgesundheitsorganisation (WHO) rund eine Million Todesfälle jährlich. Antibiotikaresistenzen würden damit zu einer der häufigsten Todesursachen weltweit werden.
Zu den problematischsten Erregern zählt Staphylococcus aureus, der Resistenzen gegen mehrere Antibiotika entwickeln kann. Solche multiresistenten Keime entstehen besonders häufig in Krankenhäusern, in denen Antibiotika regelmäßig eingesetzt werden.
Experten warnen, dass viele medizinische Eingriffe nur möglich sind, weil Antibiotika die Patienten vorbeugend schützen. Ohne wirksame Antibiotika wären schwere Infektionen wieder nicht behandelbar.
Wenn der globale Antibiotikaverbrauch nicht sinkt, droht laut Infektiologe Mathias Pletz die Rückkehr in ein „präantibiotisches Zeitalter“. Selbst Routineeingriffe oder Kaiserschnitte könnten dann wieder lebensgefährlich werden.
Wie werden neue Antibiotika klassisch entwickelt und warum reicht das oft nicht mehr aus?
Antibiotika kommen eigentlich in der Natur vor. An Orten, an denen sich zahlreiche Mikroorganismen – wie Bakterien, Pilze oder Einzeller – begegnen, herrscht eine starke Konkurrenz um Nährstoffe. Antibiotika sind ein Mittel, um sich gegen andere Mikroorganismen durchzusetzen. Deshalb suchen Forschende in Boden- oder Wasserproben nach Organismen, die solche Stoffe produzieren. Anschließend isolieren sie die potenziell wirksamen Substanzen im Labor.
Da Keime ständig neue Mechanismen entwickeln, um Antibiotika unwirksam zu machen, wird es immer schwieriger, neue, wirksame Substanzen zu finden. Forschende suchen daher gezielt in bislang wenig untersuchten oder ungewöhnlichen Lebensräumen nach antibiotischen Wirkstoffen, von Mangrovenwäldern über die Antarktis bis hin zu alltäglichen Böden. Laut César de la Fuente, dem Leiter der Machine Biology Group an der University of Pennsylvania, ist dieser Ansatz jedoch extrem arbeitsintensiv und häufig wenig erfolgreich.
Hinzu kommt ein strukturelles Problem. Fachleute wie de la Fuente sprechen von einem „kaputten Markt“. Es gebe kaum Anreize, neue Antibiotika zu entwickeln. Da sie möglichst sparsam eingesetzt werden sollen, um Resistenzen zu vermeiden, seien sie für Pharmaunternehmen im Vergleich zu Medikamenten gegen chronische Erkrankungen wenig attraktiv. Die Folge seien ein Rückzug der Industrie, weniger Studien und weniger Nachwuchswissenschaftler.
Wie kann KI helfen, neue antibiotische Wirkstoffe zu entdecken?
César de la Fuente betrachtet die Natur als riesige Datenquelle, die zeigen kann, wie neue Wirkstoffe entstehen. Die zahlreichen Bausteine wie Proteine, Aminosäuren und DNA könnten unendlich miteinander kombiniert werden. Diese Kombinationsmöglichkeiten und Wechselwirkungen seien so komplex, dass sie von Menschen kaum vollständig erfasst werden können.
De la Fuente ist überzeugt, dass KI hier helfen kann. Ein Algorithmus soll diese Muster erkennen und daraus neue antibiotische Wirkstoffe ableiten.
Das Ziel besteht darin, dass der Algorithmus nicht nur bekannte Wirkstoffe in der Natur findet, sondern auch selbst lernt, wie neue Antibiotika entstehen. Dazu orientiert er sich an den Prinzipien der Evolution und untersucht, wie sich Moleküle im Laufe der Zeit verändern und anpassen. So soll die KI in die Lage versetzt werden, neue Wirkstoffe zu entwickeln, auch gegen bislang unbekannte Erreger.
Um dieses Ziel zu erreichen, muss der Algorithmus aufwendig trainiert werden. Das Team um de la Fuente testet dazu zahlreiche Kombinationen aus Krankheitserregern und möglichen Wirkstoffen.
Das Ergebnis dieses jahrelangen Trainings ist das KI-Modell APEX. Es bewertet mögliche Wirkstoffe: Bekommt APEX den Bauplan eines Moleküls, also eine bestimmte Abfolge von Aminosäuren, berechnet das Modell in kurzer Zeit, ob dieser Stoff antibiotische Eigenschaften haben könnte. So kann der Algorithmus riesige biologische Datensätze analysieren – von menschlicher DNA über Pflanzen und Pilze bis hin zu längst ausgestorbenen Tierarten – und vielversprechende Kandidaten gezielt identifizieren.
Zunächst geht es um die Auswahl geeigneter Wirkstoffkandidaten. An solchen KI-gestützten Ansätzen zur Antibiotika-Entwicklung wird inzwischen auch an anderen Forschungseinrichtungen gearbeitet, beispielsweise am Helmholtz-Institut für Pharmazeutische Forschung Saarland.
Was sind die Grenzen von KI in der Antibiotika-Forschung?
KI kann vor allem die frühe Phase der Antibiotika-Forschung beschleunigen, in der nach neuen Wirkstoffen gesucht wird. Andreas Keller, Leiter der Abteilung Klinische Bioinformatik am Helmholtz-Institut für Pharmazeutische Forschung, ist sich sicher, dass KI bei den Antibiotika der Zukunft daher eine zentrale Rolle spielen wird.
Medikamente könnten zwar auch ohne KI entwickelt werden, so Keller, dann aber langsamer und teurer. Ob sich die bisherigen Entwicklungszeiten von 15 bis 20 Jahren durch KI deutlich verkürzen lassen, sei jedoch offen.
Gleichzeitig sind die Grenzen klar: Zunächst liefert die KI nur einen Vorschlag, nämlich den Bauplan eines möglichen Wirkstoffs, also eine bestimmte Abfolge von Aminosäuren, die laut Berechnung Bakterien abtöten könnte. Ob daraus tatsächlich ein Medikament wird, entscheidet sich erst in aufwendigen Tests im Labor, in Tierversuchen und später in klinischen Studien.
Zwar wurden inzwischen mehrere hundert KI-gestützte Wirkstoffkandidaten erfolgreich in Mausmodellen geprüft – deutlich mehr, als mit der klassischen Wirkstoffsuche möglich wäre. Doch ab diesem Punkt beginnt die lange Phase der Medikamentenentwicklung, die sich kaum noch mit KI beschleunigen lässt. César de la Fuente rechnet deshalb damit, dass es mindestens zehn Jahre dauern wird, bis ein erstes KI-Designer-Antibiotikum auf den Markt kommen könnte.
Was lässt sich gegen Antibiotikaresistenzen sonst noch tun?
Neben der Entwicklung neuer Antibiotika ist vor allem ein sparsamerer und gezielterer Einsatz zentral, um Antibiotikaresistenzen einzudämmen. Seit Jahrzehnten fordern Fachleute, Antibiotika nur dort einzusetzen, wo sie medizinisch wirklich notwendig sind – sowohl bei der Behandlung von Menschen als auch von Tieren.
In Deutschland zeigt sich bereits ein positiver Trend: Wie das Zentralinstitut für die kassenärztliche Versorgung mitteilt, ist die Zahl der Antibiotikaverschreibungen seit 2010 um knapp ein Viertel gesunken – von 559 Verordnungen pro 1000 gesetzlich Versicherten im Jahr 2010 auf 426 im Jahr 2024. Darüber hinaus betonen Fachleute die Bedeutung einer besseren Krankenhaushygiene, gezielter Schulungen für Ärztinnen und Ärzte sowie von Impfungen, die bakterielle Infektionen von vornherein verhindern können.
ema